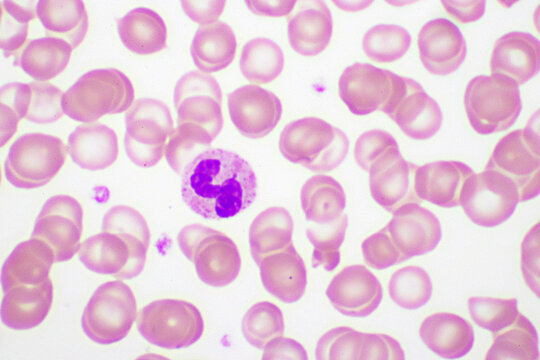
Microcyte Bilder Durchsuchen 391 Archivfotos, und

Microcleidus est un genre fossile de plésiosaures appartenant à la super-famille des Plesiosauroidea, ayant vécu au cours du Jurassique inférieur. Il fait partie de la famille des Microcleididae, dont il est l'espèce type.
Il est connu en Europe de l'ouest (France, Royaume-Uni, Allemagne, Luxembourg) dans le Toarcien, soit il y a environ entre 184,2 et 174,7 millions d'années.
Historique
Le genre Microcleidus est décrit en 1909 par le paléontologue D. M. S. Watson,.
Synonyme
Le genre Microcleidus a un synonyme Occitanosaurus Bardet et al., 1999.
Fossiles
Selon Paleobiology Database en 2024, le nombre de collections référencées de fossiles est de huit. Ces collections sont du Pliensbachien au Toarcien du Jurassique inférieur, c'est-à-dire datente de 183 à 175,6 Ma avant notre ère.
Répartition
Ces collections sont de quatre pays : une collection de France, trois collections d'Allemagne, une collection du Luxembourg et trois collections du Royaume-Uni.
Espèces
- † M. brachypterygius Huene, 1923
- † M. homalospondylus Owen, 1865
- † M. macropterus (Seeley, 1865)
- † M. tournemirensis (Sciau et al., 1990)
- † M. melusinae Vincent et al., 2019
Synonymes espèces
† M. brachypterygius
- † Hydrorion brachypterygius
- † Plesiosaurus brachypterygius
† M. homalospondylus Owen, 1865, espèce type
- † Plesiosaurus homalospondylus
† M. macropteus
- † Plesiosaurus macropteus Seeley, 1865
† M. tournemirensis
- †Plesiosaurus tournemirensis Sciau et al., 1990
- †Occitanosaurus tournemirensis Bardet et al., 1999
Description
Sa taille était comparable à celle d'un dauphin de taille moyenne, atteignant une longueur de 3 mètres. Son cou comprend 40 vertèbres et sa queue, de courte taille, 28 vertèbres.
Classification
La position de la famille des Microcleididae parmi les plésiosaures en 2012 par Roger Benson (d), Mark Evans (d) et Patrick S. Druckenmiller (d) est la suivante, :
En complément, on peut aussi consulter l'image de 2013, concernant la phylogénie complète des plésiosaures :
Suite aux retraits des deux genres Westphaliasaurus et Eretmosaurus de la famille des Microcleididae en 2013 par Benson et Druckenmiller, cette famille se réduit à deux genres :
Une nouvelle espèce, Microcleidus melusinae, basée sur un spécimen complet découvert dans le Toarcien du Luxembourg, a été décrite postérieurement en 2019.
Bibliographie
: document utilisé comme source pour la rédaction de cet article.
- (en) Ketchum HF, Benson RBJ, « Global interrelationships of Plesiosaur (Reptilia, Sauropterygia) and the pivotal role of taxon sampling in determining the outcome of phylogenetic analyses », Biological Reviews.
- (en) Hilary F. Ketchum and Roger B. J. Benson (2011), « A new pliosaurid (Sauropterygia, Plesiosauria) from the Oxford Clay Formation (Middle Jurassic, Callovian) of England: evidence for a gracile, longirostrine grade of Early-Middle Jurassic pliosaurids », Special Papers in Palaeontology 86: 109–129. doi:10.1111/j.1475-4983.2011.01083.x.
Publication originale
- [1909] (en) D. M. S. Watson, « IV. A preliminary note on two new genera of upper Liassic plesiosaurs », Memoirs and Proceedings of the Manchester Literary and Philosophical Society, vol. 54, no 4, , p. 1-28.
Voir aussi
- la liste de plésiosaures
Liens externes
Notes et références
Références taxonomiques
- (en) Paleobiology Database : †Microcleidus Watson, 1909 (plesiosaur) (consulté le )
Références
- Portail des plésiosaures
- Portail de l’Europe